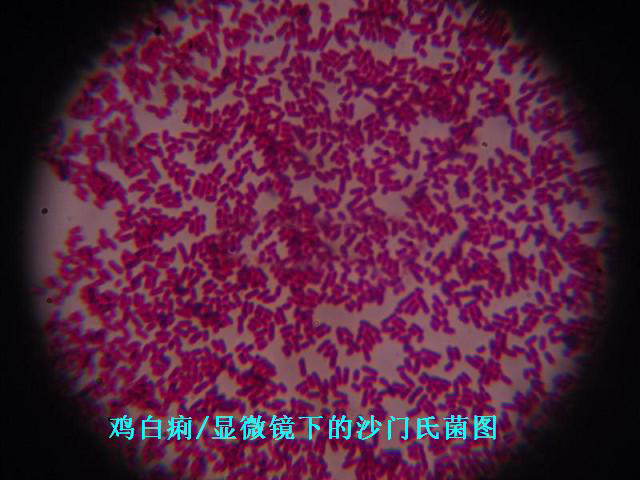

一例鸡白痢的精准诊断与有效治疗
一、发病情况
某养鸡场共存栏蛋鸡一万羽,近期鸡群采食量逐渐下降,部分鸡只精神萎靡,缩颈闭眼,羽毛松乱,翅膀下垂,排白色糊状粪便,肛门周围羽毛被粪便污染,黏连在一起。鸡群中发病率约为10%,且有逐渐上升趋势,已经出现少量死亡病例。
二、临床症状
病鸡表现为嗜睡,不愿走动,驱赶时行动迟缓。嗉囊空虚或有少量积液,鸡冠和肉髯苍白、萎缩。仔细观察粪便,可见典型的白色石灰样稀便,部分粪便呈黄绿色,带有泡沫和黏液。病鸡呼吸略显急促,但无明显的呼吸道啰音。


三、剖检变化
随机挑选几只病情较重的鸡只进行剖检。肝脏肿大,表面有散在的针尖大小灰白色坏死点;脾脏肿大,质地脆弱;肾脏肿大,有尿酸盐沉积,呈现花斑状;心肌有灰白色结节,质地较硬;肠道黏膜充血、出血,肠腔内有白色粥样内容物;卵黄吸收不良,呈黄绿色,内容物稀薄,有的病例卵黄破裂,引起腹膜炎。

四、实验室诊断
1. 细菌分离培养:无菌采集病鸡的肝脏、脾脏等组织,接种于普通琼脂培养基和麦康凯琼脂培养基,置于 37°C 恒温培养箱中培养 24 - 48 小时。在普通琼脂培养基上生长出圆形、光滑、湿润、边缘整齐、灰白色半透明的小菌落;在麦康凯琼脂培养基上生长出无色透明、圆形、光滑的小菌落。
2. 染色镜检:挑取单个菌落进行革兰氏染色,镜检可见革兰氏阴性短小杆菌,两端钝圆,单个或成对排列。
3. 生化试验:该菌能发酵葡萄糖、甘露醇,产酸不产气,不发酵乳糖、蔗糖,吲哚试验阴性,硫化氢试验阴性,尿素酶试验阴性,符合鸡白痢沙门氏菌的生化特性。
综合以上临床症状、剖检变化和实验室诊断结果,确诊该鸡群感染鸡白痢沙门氏菌。
五、治疗措施
1. 药物治疗:选用敏感抗生素恩诺沙星,按照 10%恩诺沙星可溶性粉 1 克兑水 10 公斤的比例,集中饮水,每天 2 次,连用 5 天。同时,在饲料中添加阿莫西林,按照每 1000 公斤饲料添加 100 克的剂量,连续饲喂 7 天。


2. 加强饲养管理:对鸡舍进行全面清扫和消毒,每天清理粪便,保持鸡舍清洁干燥。调整鸡群密度,加强通风换气,保证鸡舍内空气清新。提供充足的清洁饮水和营养均衡的饲料,适当增加维生素和矿物质的添加量,以增强鸡只的抵抗力。
六、治疗效果
经过 3 - 5 天的治疗,病鸡的临床症状逐渐减轻,采食量开始恢复,死亡病例明显减少。用药 7 天后,鸡群精神状态、采食量基本恢复正常,粪便也恢复正常形态。继续观察 1 周,未发现新的病例,鸡群生长发育良好,表明治疗方案有效。
七、总结与预防
本次鸡白痢的诊疗过程表明,早期准确的诊断和及时有效的治疗是控制疫情的关键。在日常饲养管理中,要加强鸡场的生物安全措施,严格执行消毒制度,防止病菌传入鸡群。定期进行鸡白痢的检疫净化工作,淘汰阳性鸡只,建立健康鸡群。同时,合理的饲养密度、良好的通风和营养均衡的饲料供应,有助于提高鸡群的免疫力,预防鸡白痢等疾病的发生。
咨技询与购买产品请联系我们术业技术员:技术联系电话:邓国景13277733727(微信同号)
带您参观助农养殖科技超市(助农兽药大药房),上千产品一站式采购养殖人的好帮手 #了解广西助农公司服务内容 #兽药、添加剂、除四害、环保处理产品一应俱全#兽医社会化服务公司

广西助农提供养殖物资供应、疾病防治净化与环保问题解决方案服务
我公司在解决养殖场疾病混合感染、疑难杂症,以及养殖场的环保与粪污资源化等问题上,公司有30多名专职兽医与畜牧人才,且有十多家兽药集团参与的技术力量与上千种兽药、疫苗、添加剂等,每天都有大量临床的经验总结。
养殖场疾病净化与技术托管、环保问题找助农公司的优点
广西助农公司是一家服务养殖业的综合服务公司,为国内超过8千家规模养殖场进行过专业服务,在广西有较高的知名度,我们的主要优势有:
1.技术力量足:几十名专业畜牧兽医技术人员,十几个集团兽药公司供应商长期派技术员驻守助农公司帮助进行专业服务。有专业的病理实验室、动物诊疗室、环保实验室等。接诊量大临床经验比一般兽药店丰富,知道当前流行疾病和更佳诊疗方案。
2.动保产品非常全面:可能是国内动保产品最全的公司,上千种规范合格的品牌兽药、消毒剂、疫苗和饲料添加剂、预混料和浓缩料,几十种解决养殖场环保及粪污资源化的产品与上百种除四害产品,上千种养殖器械、加工机器以及几十种牧草品种等。你找不到的产品在助农养殖科技超市中可能都可以找到,库存充足,且可以快速发货全国。
3.服务养殖场全面:我们不仅能够给托管养殖场解决基本当前先进的饲养技术和疾病防控(例如当前养猪最难防控的非洲猪瘟我们帮助数百多个发生疑似感染的猪场控制了下来,2千余个复养猪场运用我们的方案无一出现问题,多个规模集团运用我们的方案并给予肯定——提供真实验证,我们自己的猪场可以允许养殖同行进入猪舍内参观),还能够给托管养殖场高效率、低成本地解决粪污资源化和环保问题(我们有专业的养殖业环保实验室、几十种专业产品和大量成功案例),这是一般养殖服务公司所做不到的。
4.服务网点多:在全国有三百多个服务网点,在广西区域有近百个服务网点,托管服务我们目前仅限广西区域,不仅能够提供快捷的服务,有一定规模的养殖场货款还可以进行月结。
5.技术先进成本低:如果给广西助农公司进行猪场净化或托管,我们会依托现代生态循环养殖、发酵中草药、发酵饲料、无抗养殖、粪污全量还田种植牧草等形成生态循环等先进模式,我们的现代生态循环养殖理念先进(粪污→微生物无害化处理→全量还田种植牧草→牧草通过超细粉碎机粉碎直接饲喂或者发酵后养殖→养殖),不仅是料肉比更低,且保健成本更低,同时还能够形成高品质的动物产品,让你的养殖场获得更好的经济效益。
6.同时,由于我公司每年销售兽药量比一般兽药店要量大很多,因此进货成本更低销售给您的价格比一般兽药店销售可能降低30%左右,且临床经验要比一般兽药店更丰富,30多位兽医技术员每天汇总的临床经验能够快速知道当前流行什么疾病、什么方案用药能够达到更佳,让你少走弯路快速解决问题。对于有一定规模的养殖场,我公司可以派出技术员上门服务(助农公司从不收取上门服务费),快速解决存在的问题减少你的损失,且货款还可以月结。
【视频】助农养殖科技超市,兽药添加剂器械一站式服务
【视频】助农服务在养殖业上常用中草药展示台,几十种中草药组合配上复合益生菌酶制剂(发酵)进行使用,无抗养殖和预防疾病效果好。


广西助农畜牧科技有限公司养殖科技超市入口

经常有集团公司、养殖合作社、政府部门组团到访助农公司养殖科技超市




【视频】带您参观广西助农畜牧科技有限公司大化分公司
广西助农公司大化县宠物诊疗中心集动物诊疗、免疫、住院、美容、寄养一条龙服务。这是广西大化县第一家专业、执证宠物医院开业!欢迎您的光临!
大化县中心宠物诊疗所位于大人县兴化路139号。是广西助农畜牧科技有限公司在大化县全资投资的一所宠物诊所。填补了大化县多年来没有专业的宠物医疗机构的空白。多年来大化县的宠物看病都要到临近县都安或南宁去看病将成为历史。

【视频】广西助农生态养殖示范基地以生态养殖为核心,运用微生物技术打造了一个现代生态循环养殖场,欢迎您亲临基地现场进入猪舍、鸡舍内参观验证!
由广西助农畜牧科技有限公司建立的低成本、高效益生态循环环保庭院养殖示范基地(现代农牧生态循环科技研学示范基地),位于长寿之乡的广西壮族自治区河池市大化县(距离县城约2公里)广西助农公司生态循环养殖基地内(基地占地约130亩,年出栏肉鸡和童鸡约80万羽和约800头肉猪等),是一个以运用现代微生物技术为核心针对乡村振兴庭院养殖经济而集成的现代农业技术、生态循环、科技研学、农村经济发展于一体的综合性示范项目。我们的基地致力于推广生态循环农业模式,通过微生物技术等实现乡村庭院低成本养殖模式,形成高品质动物产品与高效益,且与环境保护和谐共生。



【视频】广西助农现代农牧生态循环科技研学示范基地喜迎大批学员到场进行研学,圆满成功 #生态养殖 #微生态养殖技术
广助农公司提供专业的养殖场环保与粪污资源化利用服务,低成本完美解决环保难题
广西助农公司有着丰富的解决养殖场环保的经验,专业配套产品全面(几十个)大量成功案例,能够针对你的养殖场进行“一场一策”制定解决方案,让你的养殖场用最少的设施投入达到解决环保、粪污资源化的目的,形成现代生态养殖循环。“公司+农户”我们可以做出解决环保与处理粪污示范,确定效果后再推广;协助政府部门进行示范建立与培训。并且提供上门服务(快速解决家禽养殖上的疾病、环保、肉品质等问题)。与国内300多个环保公司合作常年定制和运用我公司生产的产品,2万多个养殖场长期使用我们的环保产品。


【视频】广西助农养殖粪污资源化和环保服务中心,低成本快速解决环保问题
【视频】带您参观助农环保实验室,全方位快速解决环保问题#养殖环保


养殖人永远都要重视环保,特别是臭味和粪水问题。养殖场臭味大被投诉查处,运用组合微生物技术最快3天看到明显效果,快速解决你养殖场的环保问题。有一定规模养殖场广西助农公司技术员提供上门服务与标本兼治长久解决方案。




【视频】广西助农公司技术员深入养猪场一线快速解决紧急的环保问题,主要是臭味、污水、苍蝇等问题



【视频】广西助农公司技术员奔赴一线“一场一策”养殖场粪污资源化现场指导操作#助农 #粪污资源化
【视频】带你参观助农客户猪满圈,臭味少猪猪健康度高
广西助农畜牧科技有限公司联系方式

地址:广西南宁市安吉路35号A栋24、25、26号(南宁市饲料兽药禽苗市场内)
网站地址:www.zn99.com、www.fjc001.com
养殖科技超市实体店电话:0771-3815862,3800156,2204816
大客户技术支持13277883322(微信同号),微信转账请添加18076549930或15578100088为好友(还可以咨询技术与业务问题),支付宝转账13557010497(公司收款账号)。
- 上一篇:鸡霍乱综合治疗方案及防控措施 [2024-12-06]
- 下一篇:断奶仔猪到保育过程的免疫保健 措施 [2024-12-06]






